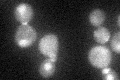
YAL041W
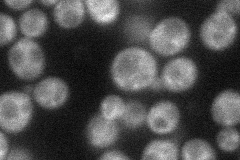
YAL041W
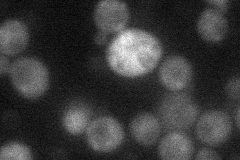
YAL041W
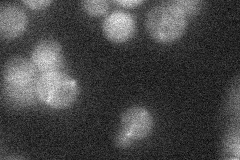
YAL041W
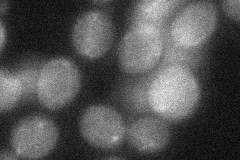
YAL041W
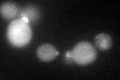
YAL041W
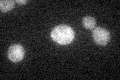
YAL041W

View description
Guanine nucleotide exchange factor (GEF or GDP-release factor) for Cdc42p; required for polarity establishment and maintenance, and mutants have morphological defects in bud formation and shmooing
Localization:
Intensity:
Fold change:
Significance:
-
C’ GFP library in SD
nucleus:cytosol:bud neckN/A -
N' NOP1pr-GFP in SD
punctate40.3329 -
N' TEF2pr-mCherry in SD
cytosol19.4526 -
N' NATIVEpr-GFP in SD
below threshold19.9098 -
N' TEF2pr-VC and Cyto-VN in SD
cytosol29.0008 -
C’ GFP library in SD+DTT
nucleus.cytosol.bud neck36.481.1No -
C’ GFP library in SD+H2O2

nucleus.cytosol.bud neck33.441.01No -
C’ GFP library in Starvation Media
cytosol28.910.87No -
C’ GFP library on the background of Pup2-DaMP

nucleus:cytosol:bud neck -
C’ GFP library on the background of CCT mutant

nucleus:cytosol:bud neck39.3421.19304No
